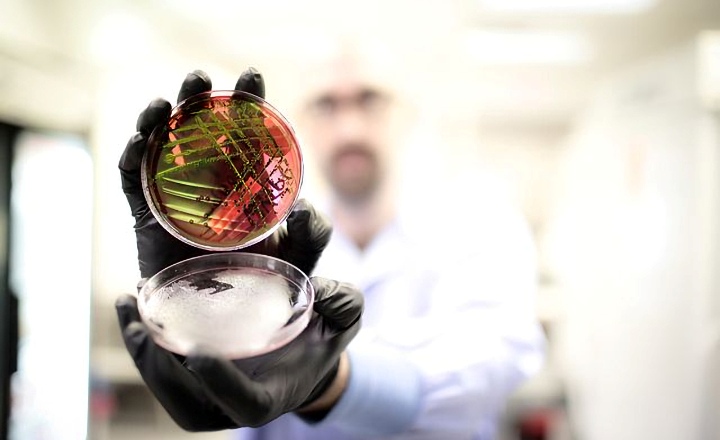

At this year's ASM meeting, Bruker introduced major innovations for strain typing, hospital hygiene and infection control.
The novel, bench-top IR Biotyper system for microbial strain typing is based on Fourier-Transform Infrared (FTIR) spectroscopy technology, and complements Bruker's world-leading MALDI Biotyper mass spectrometry platform for fast microbial identification from cultures using protein fingerprinting. The IR Biotyper uses many classes of biomolecules, like lipids, proteins, nucleic acids and polysaccharides simultaneously to characterize a microbial sample by strain-specific absorbance patterns in the infrared spectrum. Various biomolecules can contribute to this pattern, which makes the IR Biotyper an efficient tool for fast and cost-effective strain typing.
The IR Biotyper system can be used stand-alone for routine hospital hygiene and infection control, as it is capable of providing results on dozens of hygiene samples over-night, or it can be combined in a workflow with parallel microbial species identification by the MALDI Biotyper. Due to its fast time-to-result (TTR), excellent strain differentiation performance, low cost per sample, ease of use, robustness and throughput, the IR Biotyper can perfectly complement next-generation sequencing (NGS) strain-typing results, which typically require more time, training and infrastructure in core labs.
The IR Biotyper is easy to use without any prior knowledge of FTIR technology. Its workflow uses a colony from an agar plate, typically after overnight incubation. The assay needs only a few minutes of hands-on time. The complete routine workflow is supported by the new IR Biotyper Kit that allows standardized and straight-forward sample preparation, and contains proprietary test standards for quality control. The IR Biotyper supports 96-well plates, which can be used for up to 30 individual samples per run. Each sample is measured in a few minutes. The IR Biotyper software offers a simple user interface for the set-up of automated, unattended runs. The software also includes data interpretation with optimized statistical algorithms and provides clear visualization of the results, for example, as a distance matrix, or as a dendrogram of multiple isolates.
With its easy, user-friendly workflow, fast turn-around time and cost-effective sample preparation, the IR Biotyper enables new in-house workflows in hospital infection control. More samples can be analyzed prospectively in less time and at a lower cost compared to molecular technologies in hygiene laboratories. Results are generated directly after the measurements. This also improves sample logistics as many samples that previously had to be sent to central core molecular testing facilities can now be analyzed directly in the hospital hygiene laboratory. The IR Biotyper is for research-use-only and not for diagnostic use.
Dr. Jan Liese, Head of Hospital Hygiene at the University Hospital Tübingen, Germany, stated: "The spread of pathogens in hospitals, in particular of multi-resistant strains, is an increasing threat for patients' health today. The early detection of a potential outbreak is an important prerequisite to apply appropriate and timely infection control measures and to reduce the number of pathogen transmissions. We found that the IR Biotyper is an easy to use device, which features short sample analysis times and a clear data presentation. It thereby represents a promising typing tool that is suitable for a near to real-time observation of pathogen transmissions on the strain level, thereby enabling a very early intervention. This has the potential to improve patient care by prevention of hospital infections and reduction of hospital costs due to patient isolation."
In addition, Bruker also introduces a new software module for MALDI Biotyper-based subtyping. This new software detects Klebsiella pneumoniae strains carrying a plasmid that is responsible for carbapenem resistance (KPC). A novel algorithm automatically detects a specific protein peak encoded by the pKpQIL plasmid with the blaKPC gene. When activated, this optional strain detection occurs automatically during a standard microbial identification run, with simultaneous species identification and KPC strain detection results. KPC-producing Klebsiella pneumoniae strains are a severe public health problem in an increasing number of countries, and rapid methods for their detection are needed by the clinical community. The new KPC subtyping module is for research-use-only and is not for diagnostic use.
Dr. Wolfgang Pusch, Executive Vice President for Microbiology & Diagnostics at Bruker Daltonics, added: "At the ASM Microbe Meeting 2017 Bruker is further expanding its offering in clinical microbiology with innovative tools for improved infection control. While the MALDI Biotyper has its strength in fast, broad and cost-effective microbial species identification, the IR Biotyper enables fast, routine and pre-emptive strain typing in hospital hygiene and infection control. We are pleased that once again Bruker provides innovations that have high potential to improve the standard of care in hospital or other healthcare settings, while at the same time making infection control in the healthcare system more routine and more cost effective."